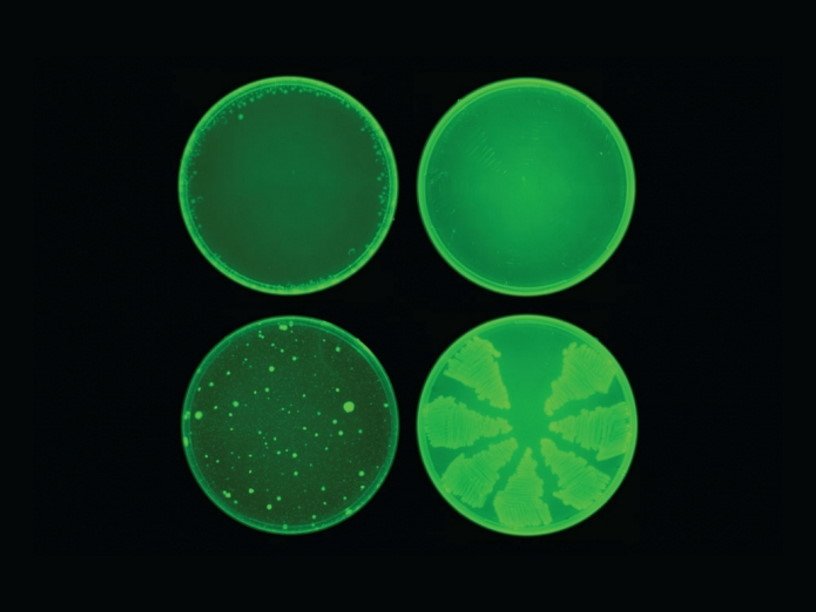

Мощный антибиотик впервые найден при помощи искусственного интеллекта
Коллектив ученых из Массачусетского технологического института сообщает, что новый антибиотик халицин, найденный при помощи технологии машинного обучения, способен справиться с некоторыми самыми опасными штаммами болезнетворных бактерий.
Компьютерная модель, которая может проверять более ста миллионов химических соединений за считаные дни, предназначена для выявления потенциальных антибиотиков, которые убивают бактерии, используя механизмы, отличные от существующих лекарств. По замыслу создателей проекта, это должно обеспечить действенность нового антибиотика по отношению к тем бактериям, которые выработали устойчивость к другим препаратам. «Мы хотели разработать платформу, которая позволила бы нам использовать возможности искусственного интеллекта, чтобы открыть новую эру открытия антибиотиков, — говорит профессор Джеймс Коллинз (James Collins). — Наш подход выявил удивительную молекулу, которая, возможно, является одним из наиболее мощных антибиотиков, когда-либо обнаруженных».
Галицин стал первым среди антибиотиков, чья формула была обнаружена при компьютерном скрининге больших цифровых библиотек химических соединений. Сначала исследователи применили метод глубокого обучения, предоставив программе информацию об атомных и молекулярных особенностях почти 2500 лекарств и природных соединений, а также о том, насколько хорошо эти вещества блокировали рост бактерии E. coli. После того как алгоритм узнал, какие молекулярные свойства заложены в хороших антибиотиках, ученые пропустили через него данные о шести с лишним тысячах химических соединений. При этом алгоритм должен был сосредоточиться на поиске веществ, которые выглядели эффективными, но отличались от существующих антибиотиков.
«Модель машинного обучения может исследовать большие количества молекулярных структур, что может быть чрезмерно дорогим для традиционных экспериментальных подходов», — говорит профессор Регина Барзилай (Regina Barzilay). Идея использования прогностических компьютерных моделей для скрининга in silico не нова, но до сих пор эти модели не были достаточно точными для открытия лекарств. Ранее молекулы в них были представлены в виде векторов, отражающих лишь наличие или отсутствие определенных химических групп.
Модель выбрала одну молекулу, которая, как предсказывалось, имела сильную антибактериальную активность, ее химическая структура отличалась от любых существующих антибиотиков. Используя другую модель машинного обучения, исследователи также показали, что эта молекула, вероятно, будет иметь низкую токсичность для клеток человека. Это вещество ранее рассматривалось как потенциальное лекарство для лечения диабета.
Найденное вещество было названо халицином, в честь системы искусственного интеллекта HAL из фильма «Космическая одиссея 2001 года». После того как предложенная искусственным интеллектом молекулярная структура была синтезирована, ее проверили на бактериальных культурах и на лабораторных мышах. Среди бактерий, которых смог уничтожить халицин, оказались устойчивые к антибиотикам Acinetobacter baumannii и Enterobacteriaceae, которые входят в список бактерий, признанных Всемирной организацией здравоохранения особо опасными. В частности использованный в исследовании штамм Acinetobacter baumannii был устойчив ко всем известным антибиотиком, но использование мази с халицином полностью излечило мышей от инфекции за сутки. Предварительные исследования предполагают, что халицин убивает бактерии, нарушая их способность поддерживать электрохимический градиент для перемещения ионов через клеточные мембраны.
После выявления халицина исследователи также использовали свою модель для скрининга более 100 миллионов молекул, выбранных из базы данных ZINC15. Скрининг, который занял всего три дня, выявил 23 кандидата, которые структурно отличались от существующих антибиотиков и, по прогнозам, были нетоксичны для клеток человека. В лабораторных тестах против пяти видов бактерий обнаружилось, что восемь молекул показали антибактериальную активность, а две были особенно сильными. Теперь исследователи планируют провести дальнейшее тестирование этих молекул, а также продолжить сканирование веществ из базы данных ZINC15. Они также планируют использовать свою модель для оптимизации существующих антибиотиков — например, обучить алгоритм, чтобы с его помощью делать определенный антибиотик направленным только на конкретных бактерий, предотвращая уничтожение им полезных бактерий в пищеварительном тракте пациента.
Исследование описано в журнале Cell.